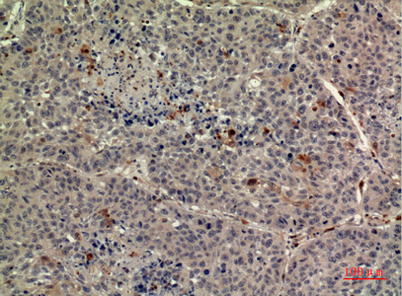

TPO rabbit pAb
 One-click to copy product information
One-click to copy product information$148.00/50µL $248.00/100µL
| 50 µL | $148.00 |
| 100 µL | $248.00 |
Overview
| Product name: | TPO rabbit pAb |
| Reactivity: | Human;Rat;Mouse; |
| Alternative Names: | THPO; MGDF; Thrombopoietin; C-mpl ligand; ML; Megakaryocyte colony-stimulating factor; Megakaryocyte growth and development factor; MGDF; Myeloproliferative leukemia virus oncogene ligand |
| Source: | Rabbit |
| Dilutions: | Western Blot: 1/500 - 1/2000. IHC-p: 1/100-1/300. ELISA: 1/20000. Not yet tested in other applications. |
| Immunogen: | The antiserum was produced against synthesized peptide derived from the Internal region of human THPO. AA range:41-90 |
| Storage: | -20°C/1 year |
| Clonality: | Polyclonal |
| Isotype: | IgG |
| Concentration: | 1 mg/ml |
| Observed Band: | 38kD |
| GeneID: | 7066 |
| Human Swiss-Prot No: | P40225 |
| Cellular localization: | Secreted. |
| Background: | Megakaryocytopoiesis is the cellular development process that leads to platelet production. The main functional protein encoded by this gene is a humoral growth factor that is necessary for megakaryocyte proliferation and maturation, as well as for thrombopoiesis. This protein is the ligand for MLP/C_MPL, the product of myeloproliferative leukemia virus oncogene. Mutations in this gene are the cause of thrombocythemia 1. Alternative promoter usage and differential splicing result in multiple transcript variants differing in the 5' UTR and/or coding region. Multiple AUG codons upstream of the main open reading frame (ORF) have been identified, and these upstream AUGs inhibit translation of the main ORF at different extent. [provided by RefSeq, Feb 2014], |
-
 Western Blot analysis of MCF-7 cells using TPO Polyclonal Antibody. Secondary antibody(catalog#:RS0002) was diluted at 1:20000
Western Blot analysis of MCF-7 cells using TPO Polyclonal Antibody. Secondary antibody(catalog#:RS0002) was diluted at 1:20000 -
 Immunohistochemical analysis of paraffin-embedded human-liver, antibody was diluted at 1:100
Immunohistochemical analysis of paraffin-embedded human-liver, antibody was diluted at 1:100 -
Immunohistochemical analysis of paraffin-embedded human-liver, antibody was diluted at 1:100
Immunohistochemical analysis of paraffin-embedded human-liver, antibody was diluted at 1:100 -
 Immunohistochemical analysis of paraffin-embedded human-liver, antibody was diluted at 1:100
Immunohistochemical analysis of paraffin-embedded human-liver, antibody was diluted at 1:100

 Manual
Manual